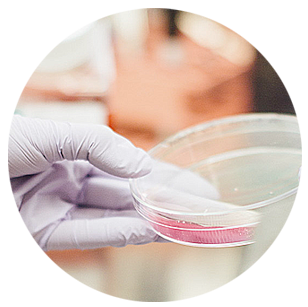

Dona,
regala vida
Con tu donativo mejoramos la calidad de vida de los enfermos de hipertensión pulmonar y apoyamos la investigación médica.
La Fundación
La Fundación Contra la Hipertensión Pulmonar (FCHP) es una entidad sin ánimo de lucro formada por enfermos, familiares y amigos de personas que padecen hipertensión pulmonar en cualquiera de sus variantes.
Nuestra misión principal es la de mejorar la calidad de vida de las personas afectadas por esta enfermedad rara, informándoles de sus características y orientándoles en el tratamiento de esta patología. Actúa a nivel nacional.
La Enfermedad

La hipertensión pulmonar es un padecimiento que provoca presión arterial alta en los vasos sanguíneos que transportan sangre a los pulmones. Cuando esto sucede, el corazón tiene que trabajar más, lo cual produce dificultad para respirar y mucho cansancio.
Investigación
Nuestra fundación es uno de los principales colaboradores del esperanzador Proyecto Empathy y además anualmente concedemos becas de investigación destinadas a apoyar proyectos científicos que buscan conseguir avances.